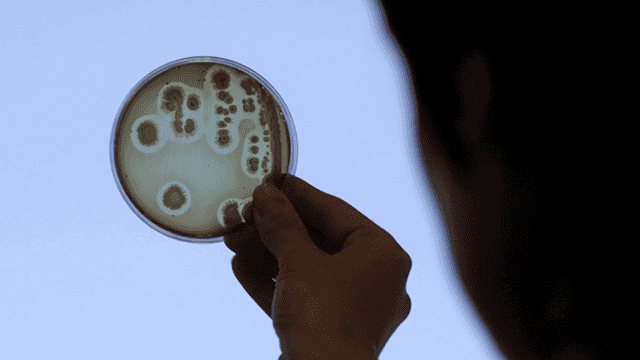
Rusia construye su propia Arca de Noé

Científicos rusos están creando un banco de ADN que contendrá información genética de todas las especies vivas del planeta, tanto las que están en peligro de extinción como las más abundantes.
El banco estará ubicado en la Universidad Estatal de Moscú y será el primero del mundo de su clase. Se prevé que esta ‘Arca de Noé’ moderna, como la llaman ya algunos científicos, esté terminada en 2018. Rusia ha asignado a la realización del proyecto 1.000 millones de rublos (194 millones de dólares), informa la agencia TASS.
La oficina de prensa de la universidad ha confirmado que el banco reunirá los biomateriales conservados por diferentes centros científicos como el Jardín Botánico, el Museo Antropológico, el Museo Zoológico y otros departamentos de la Universidad Estatal de Moscú.